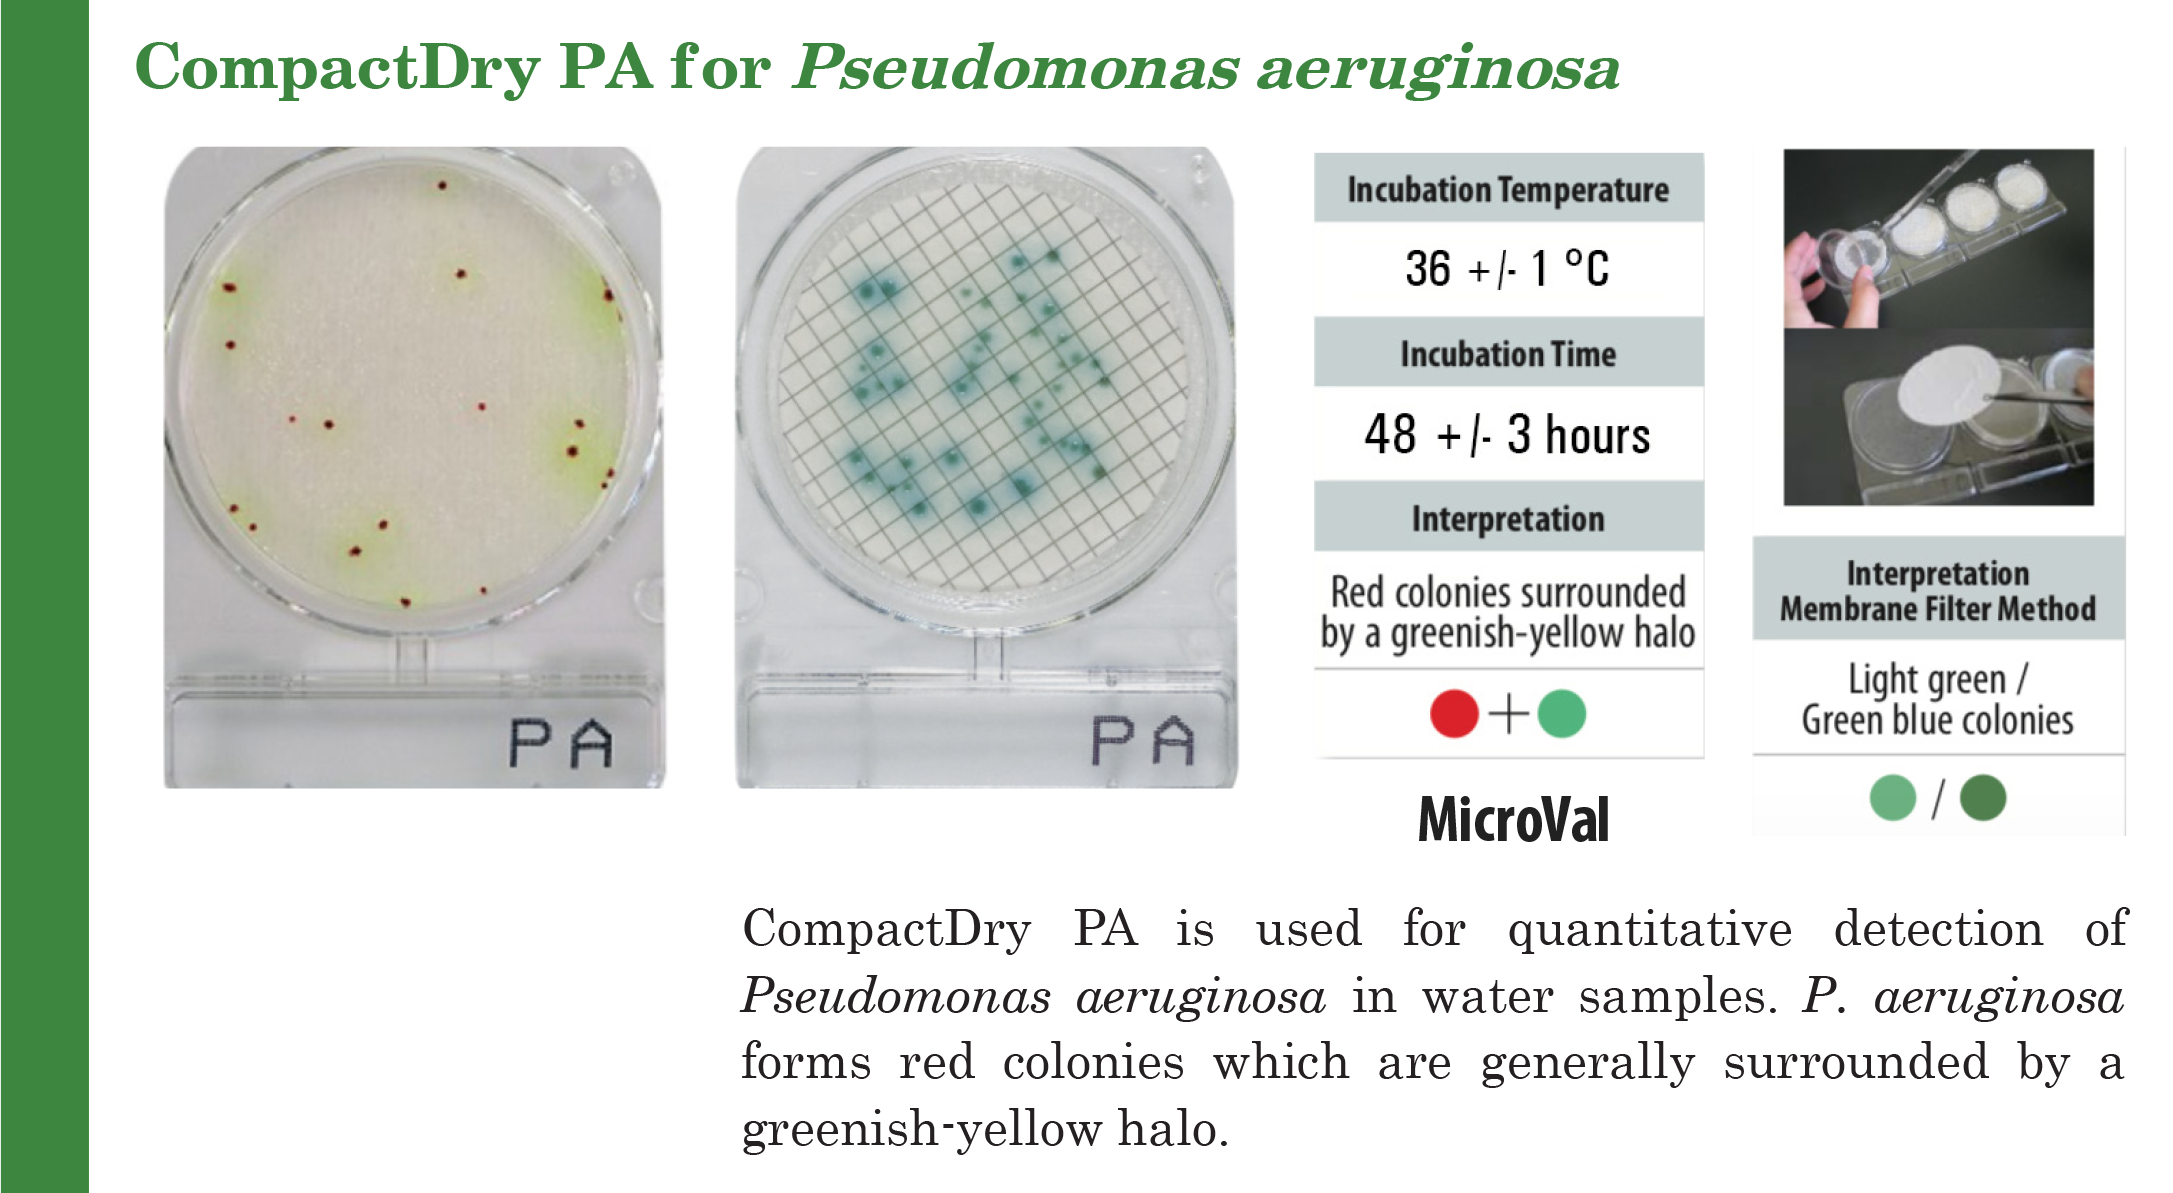
Compact Dry PA (สำหรับตรวจ Pseudomonas aeruginosa)

Compact Dry PA (สำหรับตรวจ Pseudomonas aeruginosa)
รหัสสินค้า 89-1-NIS-PA
{{show_pdata.before_vat_price_text}} (ยังไม่รวม Vat)
3,210.00 - 16,264.00 บาท
ราคาปกติ บาท
| จำนวน{{focus_pdata.unit}} | ส่วนลดต่อ{{focus_pdata.unit}} | ราคาสุทธิต่อ{{focus_pdata.unit}} |
| {{(typeof focus_pdata.price_list[idx+1] == 'undefined')?('≥ '+price_row.min_quantity):((price_row.min_quantity < (focus_pdata.price_list[idx+1].min_quantity - 1))?(price_row.min_quantity+' - '+(focus_pdata.price_list[idx+1].min_quantity - 1)):price_row.min_quantity)}} | {{number_format(((focus_pdata.price_old === null)?focus_pdata.price:focus_pdata.price_old) - price_row.price,2)}} บาท | {{number_format(price_row.price,2)}} บาท |
| {{ sub_option.name }} | - ไม่มีตัวเลือก - |
|
| คงเหลือ | 0 กล่อง | |
| จำนวน (กล่อง) |
- +
|
|
|
ซื้อเลย หยิบลงตะกร้า ซื้อเลย หยิบลงตะกร้า คุณมีสินค้าชิ้นนี้ในตะกร้า 0 กล่อง
|
||
|
|
||
| คุยกับร้านค้า | ||
| {{ size_chart_name }} |
|
|
| หมวดหมู่ | Compact Dry ตลับเพลทอาหารเลี้ยงเชื้อสำเร็จรูป | |
| สภาพ | สินค้าใหม่ | |
| เพิ่มเติม | ||
| สภาพ | สินค้ามือสอง | |
| เกรด | ||
| สถานะสินค้า | ||
| ระยะเวลาจัดเตรียมสินค้า | ||
| เข้าร่วมโปรโมชั่น | ||
*ราคาสินค้ารวมภาษีมูลค่าเพิ่ม (vat 7 %) แล้ว
วิธีการส่งสินค้า
| สินค้า | ราคา (รวมvat) | เงื่อนไข |
| สินค้าปกติ |
107 บาท |
สั่งซื้อ 3,000 บาทขึ้นไปส่งฟรี |
| สินค้าแช่เย็น | 214 บาท |
ทุกคำสั่งซื้อ |
*สินค้าที่ต้องแช่เย็น เช่น ชุดทดสอบหายาฆ่าแมลง, ชุดทดสอบสารก่อภูมิแพ้ เป็นต้น ซึ่งจะมีระบุอยู่ที่เงื่อนไขอื่นๆด้านล่างหน้าสินค้านั้นนะคะ
*โปรดเลือกวิธีการส่งให้ตรงกับสินค้าที่ซื้อ มิฉะนั้นจะไม่สามารถทำการจัดส่งสินค้าให้ได้ค่ะ
รายละเอียดสินค้า
| ข้อมูล |
น้ำหนัก
บาร์โค้ด
ลงสินค้า
อัพเดทล่าสุด
|
| รายละเอียดสินค้า |
Compact Dry PA (สำหรับตรวจ Pseudomonas aeruginosa)
คำอธิบาย
เป็นจานอาหารเลี้ยงเชื้อสำเร็จรูป สำหรับตรวจหาเชื้อ Pseudomonas aeruginosa ประกอบด้วยอาหารเลี้ยงเชื้อสำเร็จรูปแบบแห้ง และสารบ่งชี้ที่มีความจำเพาะเจาะจง
คุณสมบัติ
ข้อมูลจำเพาะ
APPROVED
PACKAGE
compactdry pa, compact dry pseudomonas, pseudomonas aeruginosa test kit, compact dry pa plate, pa bacteria detection, คอมแพคดราย PA, ชุดตรวจซูโดโมแนส, ตรวจเชื้อ pseudomonas, เพลทตรวจ PA, ตรวจอาหาร PA |
| เงื่อนไขอื่นๆ |
|
| Tags |
วิธีการชำระเงิน
ชำระเงินผ่านธนาคาร
ชำระเงินด้วยการ Scan QR



บริษัท บี สมาร์ท ซายเอ็นซ์ จำกัด
012-xxxxxx-2
Accept All Banks | รับเงินได้จากทุกธนาคาร
นโยบายการเปลี่ยนหรือคืนสินค้า
เงื่อนไขการเปลี่ยน/คืนสินค้า
หากสินค้ามีปัญหากรุณาติดต่อมาที่ Line ID : @bsma หรือ โทร 02-4493941
- บริษัทฯ ยินดีรับเปลี่ยน/คืนสินค้า ภายใน 7 วันทำการนับตั้งแต่ลูกค้าเซ็นรับสินค้า หากเกินจากวันเวลาดังกล่าว บริษัทฯ ขอสงวนสิทธิ์ในการไม่รับเปลี่ยน/คืนสินค้า
- ทางบริษัทขอสงวนสิทธิ์ในการไม่รับเปลี่ยนสินค้าคืนทุกกรณี เช่น ลูกค้าไม่พึงพอใจในตัวผลิตภัณฑ์สินค้า ลูกค้าต้องการเปลี่ยนสินค้าข้ามรุ่น หรือลูกค้าสั่งซื้อสินค้าผิด
- ลูกค้าจะต้องถ่ายวิดิโอขณะแกะกล่องพัสดุ แบบคลิปเดียวจบ ไม่มีตัดต่อ หากไม่มีวิดิโอยืนยัน บริษัทฯ ขอสงวนสิทธิ์ในการไม่รับเปลี่ยน/คืนสินค้า
- ลูกค้าจะต้องทำการจัดส่งสินค้ากลับมายังบริษัทฯ โดยที่สินค้าที่ต้องการเปลี่ยน/คืนจะต้องอยู่ในสภาพสมบูรณ์ ไม่ชำรุดเสียหายจากการใช้งาน
- บริษัทฯ ขอสงวนสิทธิ์ในการพิจารณาตรวจสอบสภาพสินค้าที่ลูกค้าส่งกลับคืนมาก่อนจัดส่งสินค้าชิ้นใหม่ให้แก่ลูกค้า
- บริษัทฯ ขอสงวนสิทธิ์ในการรับเปลี่ยนสินค้าภายใต้นโยบายและเงื่อนไขตามที่บริษัทฯ กำหนดเท่านั้น
- สินค้าผิดรุ่น สินค้าผิดสี สินค้าไม่ตรงตามสเปค
- สินค้ามีสภาพชำรุด เสียหาย หรือไม่สามารถใช้งานได้ตั้งแต่ได้รับสินค้า
หากสินค้ามีปัญหากรุณาติดต่อมาที่ Line ID : @bsma หรือ โทร 02-4493941
กรุณาเลือกแบบสินค้าก่อนสั่งซื้อ
Compact Dry PA (สำหรับตรวจ Pseudomonas aeruginosa)
ราคาปกติ บาท
| - ไม่มีตัวเลือก - |
|
|
| คงเหลือ | 0 กล่อง | |
| จำนวน (กล่อง) |
- +
|
|
|
ไม่มีสินค้าที่เลือก
กรุณาเลือกแบบสินค้าก่อนสั่งซื้อ
ซื้อเลย หยิบลงตะกร้า คุณมีสินค้าชิ้นนี้ในตะกร้า 0 กล่อง
|
||
Related to items you've viewed
 บริษัท บี สมาร์ท ซายเอ็นซ์ จำกัด
บริษัท บี สมาร์ท ซายเอ็นซ์ จำกัด
{{is_joined?'เป็นสมาชิกแล้ว':'Join เป็นสมาชิกร้าน'}}
384
สมัครสมาชิกร้านนี้ เพื่อรับสิทธิพิเศษ
ร้านค้าออนไลน์
Inspired by
LnwShop.com (v2)
▲
▼
รายการสั่งซื้อของฉัน
รายการสั่งซื้อของฉัน
ข้อมูลร้านค้านี้

บริษัท บี สมาร์ท ซายเอ็นซ์ จำกัด
ศูนย์รวม เครื่องมือ เคมีภัณฑ์ อุปกรณ์วิทยาศาตร์ ชุดทดสอบสารปนเปื้อนใน อาหาร น้ำ ยา ดิน เครื่องสำอาง เพื่อใช้ในห้องแล็บ โรงงานอุตสาหกรรม ด้านเกษตร การเรียนการสอนในโรงเรียน งานราชการ เอกชน และ ประชาชนทั่วไป
เบอร์โทร : 02-4493941
อีเมล : bsmartsci@gmail.com
อีเมล : bsmartsci@gmail.com
ส่งข้อความติดต่อร้าน
เกี่ยวกับร้านค้านี้
ค้นหาสินค้าในร้านนี้
ค้นหาสินค้า
สินค้าที่ดูล่าสุด
บันทึกเป็นร้านโปรด
Join เป็นสมาชิกร้าน
แชร์หน้านี้
แชร์หน้านี้
↑
TOP เลื่อนขึ้นบนสุด
TOP เลื่อนขึ้นบนสุด
คุณมีสินค้า 0 ชิ้นในตะกร้า สั่งซื้อทันที
สินค้าในตะกร้า ({{total_num}} รายการ)

ขออภัย ขณะนี้ยังไม่มีสินค้าในตะกร้า
ราคาสินค้าทั้งหมด
฿ {{price_format(total_price)}}
- ฿ {{price_format(discount.price)}}
ราคาสินค้าทั้งหมด
{{total_quantity}} ชิ้น
฿ {{price_format(after_product_price)}}
ราคาไม่รวมค่าจัดส่ง
รวมภาษีมูลค่าเพิ่มแล้ว
➜ เลือกซื้อสินค้าเพิ่ม



